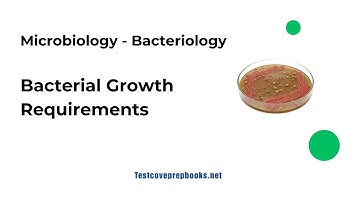
Bacterial Growth Requirements | Bacteriology | ASCP MLS Prep

⬇ DOWNLOAD NOW
Kalau muncul iklan pop-up, tutup lalu klik tombol kembali
Download lagu ASCP Study Guide: Complete Bacterial Structure Review | MLS MLT Prep secara gratis hanya untuk keperluan promosi. Dukung artis favorit kamu dengan membeli musik original di iTunes atau platform resmi lainnya.
 ASCP-microbiologiemodule: Inleiding tot klinische microbiologie | Voorbereiding op het examen med...
ASCP-microbiologiemodule: Inleiding tot klinische microbiologie | Voorbereiding op het examen med...
 ASCP Microbiology Course PRACTICE QUESTIONS
ASCP Microbiology Course PRACTICE QUESTIONS
 ASCP Exam Prep: Medical Microbiology Part 1 |
ASCP Exam Prep: Medical Microbiology Part 1 |
 Bacterial Structure and Functions
Bacterial Structure and Functions
 Urine Microscopy quiz,lab quiz, lets start :)
Urine Microscopy quiz,lab quiz, lets start :)
 ASCP Exam Prep: Medical Microbiology Part 2 | Stains, Culture Media, Specimen Collection & Handling
ASCP Exam Prep: Medical Microbiology Part 2 | Stains, Culture Media, Specimen Collection & Handling
Bacterial Growth Requirements | Bacteriology | ASCP MLS Prep
Bacterial Growth Requirements | Bacteriology | ASCP MLS Prep
 Agar plate streaking
Agar plate streaking